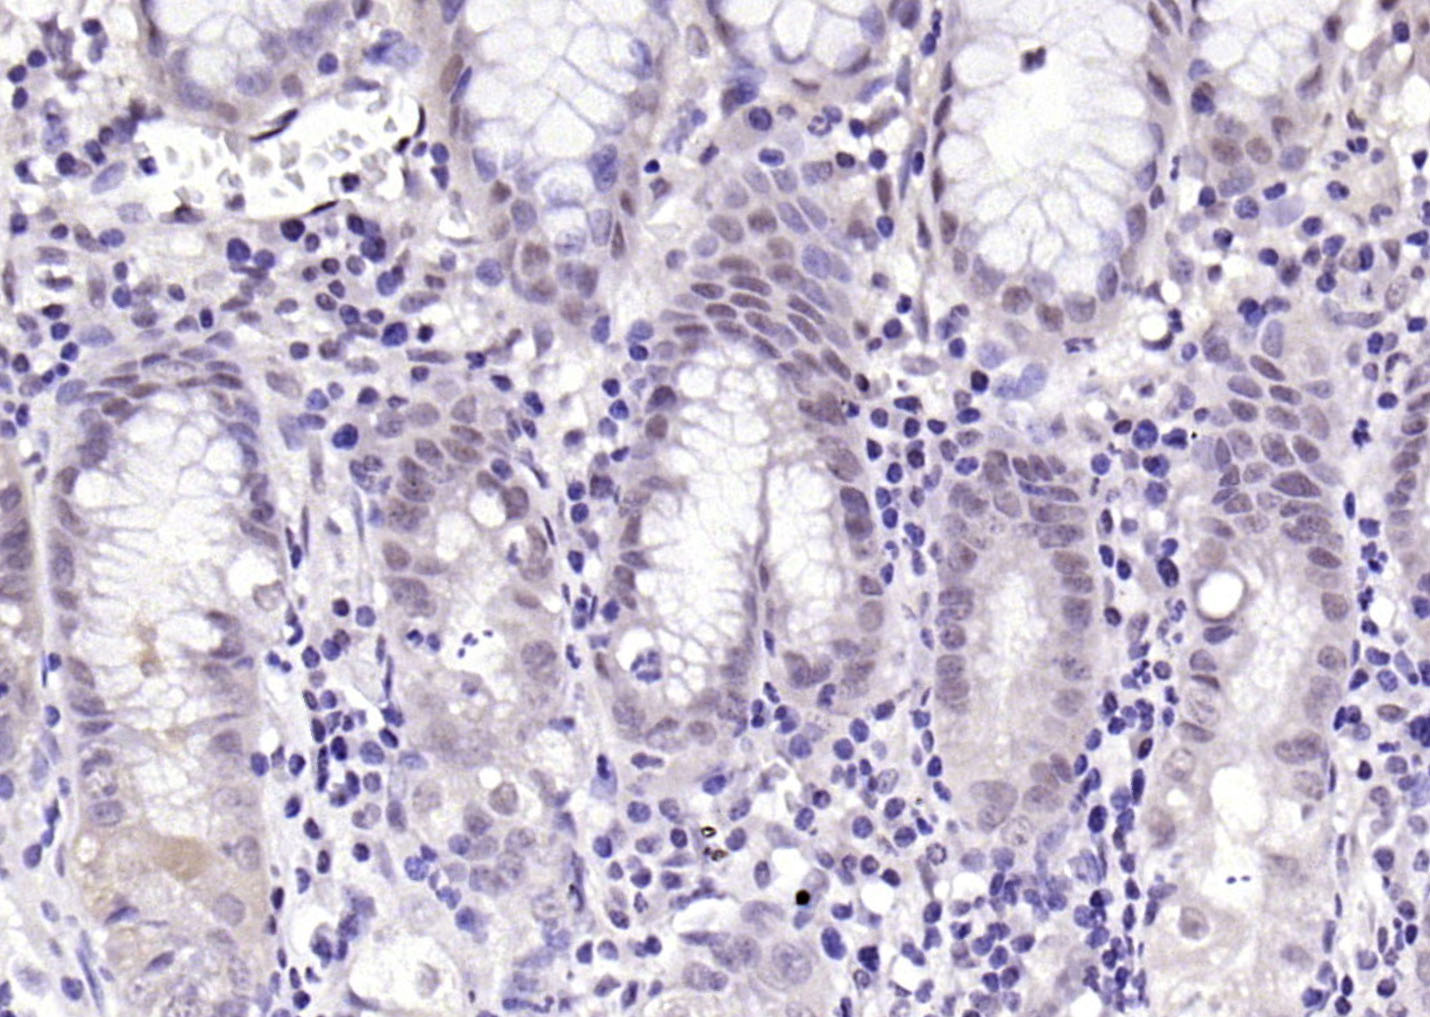
phospho-Parkin (Ser131) Rabbit

相关产品推荐更多 >

MED19/LCMR1 Rabbit pAb(bs-18765R)-50ul/100ul/200ul
¥1180
NALP5 Rabbit pAb, HRP conjugated(bs-19006R-HRP)-100ul
¥2980
TUBB3 (Neuronal Marker) Rabbit pAb, Cy3 conjugated(bs-4512R-Cy3)-100ul
¥2980
Growth hormone receptor Rabbit pAb, BF555 conjugated(bs-0654R-BF555)-100ul
¥2980
LRRC34 Rabbit pAb(bs-18380R)-50ul/100ul/200ul
¥1180
万千商家帮你免费找货
0 人在求购买到急需产品
- 详细信息
- 文献和实验
- 技术资料
- 应用范围:
产品信息以Bioss网站为准
- 规格:
50ul/100ul/200ul
| 规格: | 50ul | 产品价格: | ¥1180.0 |
|---|---|---|---|
| 规格: | 100ul | 产品价格: | ¥1980.0 |
| 规格: | 200ul | 产品价格: | ¥2800.0 |
| 产品编号 | bs-19881R |
| 英文名称 | phospho-Parkin (Ser131) Rabbit pAb |
| 中文名称 | 磷酸化帕金森病蛋白2抗体 |
| 英文别名 | Parkin(phospho S131); p-Parkin(phospho S131); AR JP; E3 ubiquitin ligase; E3 ubiquitin protein ligase parkin; E3 ubiquitin-protein ligase parkin; FRA6E; LPRS 2; LPRS2; PARK 2; PARK2; Parkin 2; Parkinson disease(autosomal recessive juvenile) 2; Parkinson disease(autosomal recessive, juvenile) 2, parkin; Parkinson disease protein 2; Parkinson juvenile disease protein 2; Parkinson protein 2 E3 ubiquitin protein ligase; Parkinson protein 2, E3 ubiquitin protein ligase(parkin); PDJ; PRKN 2; PRKN; PRKN2; PRKN2_HUMAN; Ubiquitin E3 ligase PRKN. |
| 产品应用 | IHC-P=1:100-500, IHC-F=1:100-500, IF=1:100-500 Not yet tested in other applications. |
| 交叉反应 | Human (Cow) |
| 抗体来源 | Rabbit |
| 免疫原 | KLH conjugated synthesised phosphopeptide derived from human Parkin around the phosphorylation site of Ser131 |
| 亚型 | IgG |
| 性状 | Liquid |
| 纯化方法 | affinity purified by Protein A |
| 克隆类型 | Polyclonal |
| 理论分子量 | 52 kDa |
| 浓度 | 1mg/ml |
| 储存液 | 0.01M TBS (pH7.4) with 1% BSA, 0.02% Proclin300 and 50% Glycerol. |
| 研究领域 | Cell Biology > Proteolysis / Ubiquitin > Proteasome / Ubiquitin > Ubiquitin E3 Enzymes > RING Finger E3 Ligase Metabolism > Pathways and Processes > Mitochondrial Metabolism > Mitophagy fission and fusion Neuroscience > Neurology process > Neurodegenerative disease > Parkinson's disease > Parkin / PARK |
| 亚基 | Forms an E3 ubiquitin ligase complex with UBE2L3 or UBE2L6. Mediates 'Lys-63'-linked polyubiquitination by associating with UBE2V1. Part of a SCF-like complex, consisting of PARK2, CUL1 and FBXW7. Interacts with SNCAIP. Binds to the C2A and C2B domains of SYT11. Interacts and regulates the turnover of SEPT5. Part of a complex, including STUB1, HSP70 and GPR37. The amount of STUB1 in the complex increases during ER stress. STUB1 promotes the dissociation of HSP70 from PARK2 and GPR37, thus facilitating PARK2-mediated GPR37 ubiquitination. HSP70 transiently associates with unfolded GPR37 and inhibits the E3 activity of PARK2, whereas, STUB1 enhances the E3 activity of PARK2 through promotion of dissociation of HSP70 from PARK2-GPR37 complexes. Interacts with PSMD4 and PACRG. Interacts with LRRK2. Interacts with RANBP2. Interacts with SUMO1 but not SUMO2, which promotes nuclear localization and autoubiquitination. Interacts (via first RING-type domain) with AIMP2 (via N-terminus). Interacts with PSMA7 and RNF41. Interacts with PINK1. |
| 亚细胞定位 | Cytoplasm, cytosol. Nucleus. Endoplasmic reticulum. Mitochondrion. Note=Mainly localizes in the cytosol. Co-localizes with SYT11 in neutrites. Co-localizes with SNCAIP in brainstem Lewy bodies. Relocates to dysfunctional mitochondria that have lost the mitochondrial membrane potential; recruitment to mitochondria is PINK1-dependent. |
| 组织特异性 | Highly expressed in the brain including the substantia nigra. Expressed in heart, testis and skeletal muscle. Expression is down-regulated or absent in tumor biopsies, and absent in the brain of PARK2 patients. Overexpression protects dopamine neurons from kainate-mediated apoptosis. Found in serum (at protein level). |
| 翻译后修饰 | Auto-ubiquitinates in an E2-dependent manner leading to its own degradation. Also polyubiquitinated by RNF41 for proteasomal degradation.
S-nitrosylated. The inhibition of PARK2 ubiquitin E3 ligase activity by S-nitrosylation could contribute to the degenerative process in PD by impairing the ubiquitination of PARK2 substrates. |
| 相似性 | Belongs to the RBR family. Parkin subfamily. Contains 1 IBR-type zinc finger. Contains 2 RING-type zinc fingers. Contains 1 ubiquitin-like domain. |
| 功能 | Functions within a multiprotein E3 ubiquitin ligase complex, catalyzing the covalent attachment of ubiquitin moieties onto substrate proteins, such as BCL2, SYT11, CCNE1, GPR37, STUB1, a 22 kDa O-linked glycosylated isoform of SNCAIP, SEPT5, ZNF746 and AIMP2. Mediates monoubiquitination as well as 'Lys-48'-linked and 'Lys-63'-linked polyubiquitination of substrates depending on the context. Participates in the removal and/or detoxification of abnormally folded or damaged protein by mediating 'Lys-63'-linked polyubiquitination of misfolded proteins such as PARK7: 'Lys-63'-linked polyubiquitinated misfolded proteins are then recognized by HDAC6, leading to their recruitment to aggresomes, followed by degradation. Mediates 'Lys-63'-linked polyubiquitination of SNCAIP, possibly playing a role in Lewy-body formation. Mediates monoubiquitination of BCL2, thereby acting as a positive regulator of autophagy. Promotes the autophagic degradation of dysfunctional depolarized mitochondria. Mediates 'Lys-48'-linked polyubiquitination of ZNF746, followed by degradation of ZNF746 by the proteasome; possibly playing a role in role in regulation of neuron death. Limits the production of reactive oxygen species (ROS). Loss of this ubiquitin ligase activity appears to be the mechanism underlying pathogenesis of PARK2. May protect neurons against alpha synuclein toxicity, proteasomal dysfunction, GPR37 accumulation, and kainate-induced excitotoxicity. May play a role in controlling neurotransmitter trafficking at the presynaptic terminal and in calcium-dependent exocytosis. Regulates cyclin-E during neuronal apoptosis. May represent a tumor suppressor gene. |
| 保存条件 | Shipped at 4℃. Store at -20℃ for one year. Avoid repeated freeze/thaw cycles. |
| 注意事项 | This product as supplied is intended for research use only, not for use in human, therapeutic or diagnostic applications. |
| 背景资料 | Parkinson's Disease, the second most common neurodegenerative disease after Alzheimer's Disease, is characterized by the loss of dopaminergic neurons and the presence of Lewy bodies (comprised of alpha synuclein and parkin inclusions). Autosomal Recessive Juvenile Parkinsonism (AR-JP) is a recently described form of Parkinson's Disease that has been linked to a gene that codes for parkin. Parkin, a 52 kDa protein, has a suggested role in the ubiquitin/proteasome pathway for protein degradation. The amino terminus bears sequence homology to ubiquitin while functionally it acts as a RING type ubiquitin protein ligase (E3) that coordinates the transfer of ubiquitin to substrate proteins, thus targeting them for degradation by the proteasome. |
| 应用 | 推荐稀释比例 |
| {IHC-P} | {1:100-500} |
| {IHC-F} | {1:100-500} |
| {IF} | {1:100-500} |

风险提示:丁香通仅作为第三方平台,为商家信息发布提供平台空间。用户咨询产品时请注意保护个人信息及财产安全,合理判断,谨慎选购商品,商家和用户对交易行为负责。对于医疗器械类产品,请先查证核实企业经营资质和医疗器械产品注册证情况。
文献和实验:使用 Anti-phospho-Akt (Ser473) Rabbit mAb 对石蜡包埋的人乳腺癌组织进行免疫组织化学分析。(图 A)使用免疫组化试剂盒M&R HRP/DAB Detection IHC Kit,抗体 1:100 稀释;(图 B) 采用普通免疫组化试剂盒,抗体 1:25 稀释。 图 6 免疫组化实验检测 Erk1/2 表达 注:使用 Anti-Erk1/2 Mouse mAb与p44/42 MAPK (Erk1/2)Rabbit mAb 对正常小鼠心脏组织进行免疫
at 10, 25, and 50 μM). At 24 h post-treatment, celllysates were obtained; SDS-PAGE and Western blotting were performed as described in Section 3, Methods. AR-A014418dose-dependent decreases of phospho-β-catenin (Ser33/37) and phospho-glycogen synthase
(Ser473)(193H12)Rabbit mAb,1:300,稀释,二抗是驴抗兔,1:2000,我是实验室的新手,刚呆俩月,受 此挫折,一头雾水,请过来人或者有经验的同学帮忙解答怎样解决,非常感谢! 碧峤 pAkt有两个位点,Ser473和Thr308,其中Ser473相对容易显色。如果显色失败,可能的原因:1 上样量过少,我们一般都是30μg;2 一抗孵育时间过短,我们一般24h~48h;3 一抗是否工作有待排除 米宝
技术资料暂无技术资料 索取技术资料






